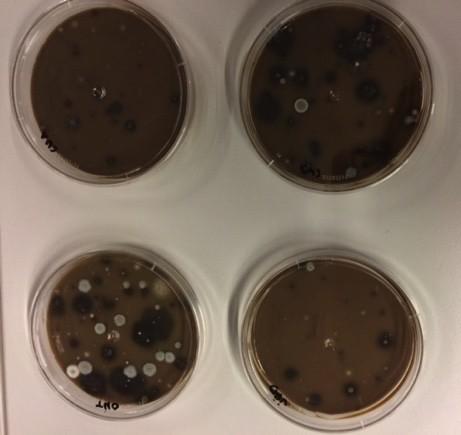
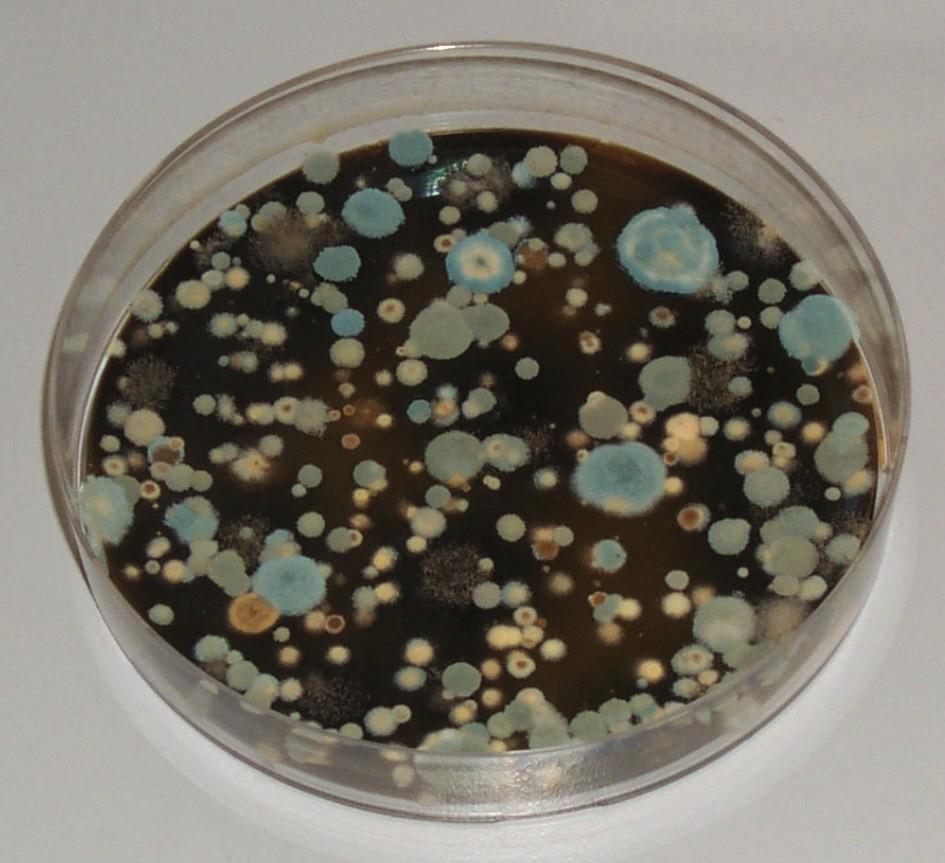
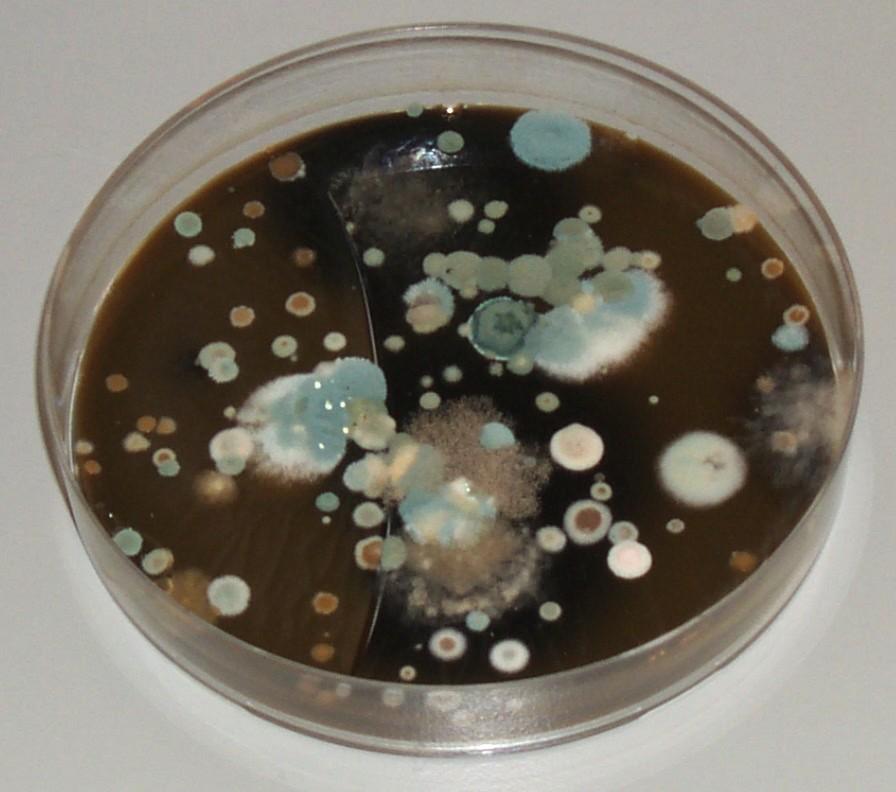
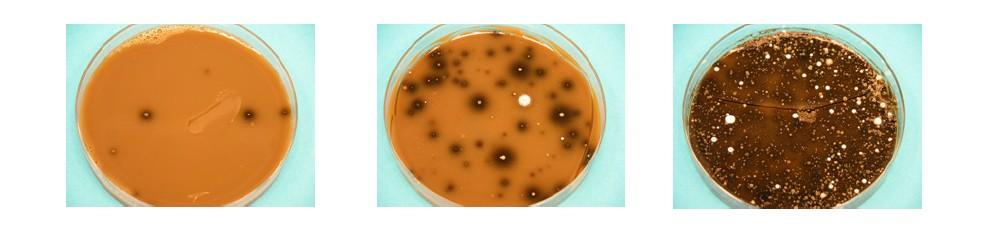

3 Sessions of 2 hours
Dates, times and subjects:
25 + 26 + 27 /08/2025 :
4 - 6 pm UAE Time = 2 – 4 pm in Holland: 2hrs session
Oktober examn with Kahoot + certificates
People receiving flowers
Quality teams (compliance and checking teams)
Operations teams storing, processing the flowers
General information about cut flower assortment
Specifications of flowers: ripeness stages
The chain for cut flowers and the influence on quality:
3 Sessions – Temperature and humidity
Botrytis and bacteria
Transport conditions and packaging
Quality checks after products arrives in Floward
How to put flowers on water:
– care and handling / effects of flower food
– workflows / instructions
How to store products in Floward / effects of flower food
Assortment: explanation about several important cut flowers:
– Rosa, Tulipa, Hydrangea, Lilium, Etc etc
Let’s introduce: Lucas Jansen Floweracademy.nl: courses & training sessions
– Assortment knowledge
– Quality knowledge + Entrance control
– Marketing + retail marketing
– Category management
– Account management
– Floral art courses abroad
– Market research / retail safaris
HIG; horti-inspiration-group (networking)
Input / knowledge helpdesk Flowercouncil
– Campaign calenders
– Helpdesk/ advice
Active in Holland and abroad (29 countries)
Author textbooks MBO education
– Florist of the future
– Quality in te chain
In 4 countries Database InfoFlowersPlants Account on Webapp
InfoFlowersPlants with possibilities to search and find the assortment in the various product groups Including interesting facts such as origin, care, symbolism, location, etc.
You will receive an email with 3 steps to create your own password for this platform
Social Media Lucas Lets start to learn Floward education plan
The chain of flowers: Breeder
Producers / growers:
worldwide assortment
Transporter
Export: package products
Transport by plane
Arrive Floward: care + handling
Online sales Floward web shops
Happy consumers
Most important import countries Harvesting Sunflowers Productie depends on country and region Holland: sea level
Kenia: 1500 – 2000 meter high Ecuador: 2000 – 3000 meter high
The production and variety has influence on:
Size of buds
Growth rate / tempo Opening of flowers
Holland production: Rosa Jumilia Rose production Kenia Most important flowers Floward Rosa
Spray
single in different headsizes)
Tulipa
Chrysanthemum (spray, disbud, santini)
Lilium
Paeonia
Alstroemeria
Hippeastrum syn. Amaryllis
Classification cut flowers Main crops Of these 3 bunch and disbudded versions for:
• Rosa
• Chrysanthemum
• Dianthus
Gerbera
• Always 1 flower on 1 stem
Alstroemeria
• Always several flowers on 1 stem
Trend is more spray roses https://issuu.c om/united-sel ections/docs/s prays_brochur e_2025_us
Floward education plan
Bulb flowers Spring flowering bulbs:
• Tulipa
• Hyacinthus
• Narcissus
• Hippeastrum
• Muscari
Summer-flowering bulbous plants:
• Dahlia
• Iris
• Gladiolus
• Lilium
• Ornithogalum
• Freesia
• Ranunculus
Types of Lilium Lilium Exotic flowers: Pretty much only imports Exotic flowers annual share from greenhouse NL Exotic flowers partly Dutch and partly import Exotic flowers mostly from the Netherlands, sometimes imports Forest schrubs: Forced Cut Flowers Summer flowers from annuals Impression Flower production Summer flowers from annuals Summer flowers from perennials Summer flowers from perennials Decorative foliage Availability cut flowers Rosa (spray and single roses differen head sizes
around Tulipa
around
Chrysanthemum (spray, disbud, santini) Year around
Lilium
Paeonia
Alstroemeria
around
The chain of flowers The chain of flowers: Breeder
Producers / growers:
worldwide assortment
Transporter
Export: package products
Transport by plane
Arrive Floward: care + handling
Online sales Floward web shops
Export company OZ-Export: wide assortment Export company OZ-Export Export Holland Quality control export company On the sticker its on what is in the box S1 =
S2 =
length of flowers how many buds
Quality Groups in flowers AA = super best quality
the purchasers of OZ select this flowers from the best growers in the most best quality you can have
A1 = very good quality
It’s an quality group used in the whole business
Quality of products is without any negative comments
Most of the products of OZ are sold in A1 quality A2 = quality ok
Its ok quality but some small comments can be on the products. By example:
– Some flowers have curved stems
– Flowers are not uniform
– Some leaves have leave tips
– Etc
B1 = Not sold by OZ
– quality most of the time not ok
S-codes: app floribook Specifications plants flowers Pot size
Sorted by:
Height, diameter, number of branches / cutting per pot,
Number of flowers / buds, shape, lenght of tendrils etc.
Uniformity
Maturity / ripeness stage
Well hardened
Well rooted
Pot enough moistured
Free of pests and diseases
Length
Sorted by:
Weight, diameter, size
Number of flowers / buds
Uniformity
Maturity / ripeness stage
Free of pests and diseases
Sprecification codes: in app floribook Influences quality in the chain Ripeness stages Ripeness stage: purchase stage and consumer perceptions Lily ripeness: Asian + Longiflorum Lily ripeness: Oriental Ripeness How more raw how longer the vase life?
NO:
– mostly it’s better to buy the stadium of a flower which give the possibility to flowering totally open
BUT:
– Each flower has own ripeness stadium – This depends on:
Genus
Variety
Time of the year
Knowledge and information: – To which part of the flower you have to look
Ripeness stage of roses Relationship too immature and don't open Flower is present in the smallest bud Bud unfolding for flowering needed: water sucking cells come on voltage 7 x original bud weight energy needed drawn from the sugars in the petals
Shortage of sugars: reserve source appeal to starch granules in the petals undetectable laboratory
Relationship too immature and don't open With insufficient starch no efflorescence
Roses cut too young, too little starch
Too little starch after water after ripened roses
Store too long at too high temperature Flowers have to breathe and consume too little starch in sugars and starches
Ripeness stages Lilium Ripeness stages Lilium Ripeness of the flower: Lilium Ripeness of the flower: Anthurium Ripeness of the flower: Cymbidium Gerbera ripeness stadium: the rings in the flower 2-3 rings is ok To Ripe Quality Check after delivering Floward Use checklists Floward Floward handling The chain of flowers: Breeder
Producers / growers:
worldwide assortment
Transporter
Export: package products
Transport by plane
Arrive Floward: care + handling
Online sales Floward web shops
Happy consumers
Why cooling? Less ethylene production
Less grown of bacteria Less evaporation
Slower come open of the flower Less wound healing
Temperature of products – With cooling we reduce the insensitivity of breathing of the flower
• A temperature which is 10 degrees lower, the flower will breath 2 – 3 times lower
Storage of flowers Fresh nesh of products in very important FIFO = first in – first out
Reduce failure Trolley with rest products cost much money
How more rest products – how more waste
Indication: 3000-4000 euro a week = waste
Optimal cold store temperatures Very important: cool chain Pallets with flowers Quality of flowers which arrives depending on How cold the flowers goes into the box
How is the cool chain
Way of stacking / pelletizing
Will temperature increase or decrease?
Flowers produce heat by themselves
How long the product / box will be on the road
What material to put in the box to prevent heat / cold temperature
What happens in a box when temperature increase? Products will get more ripe
Some products will curve stems
– Specially some typical products
More evaporation = – loss of moisture – = loss of quality
More condensation = – higher change on Botrytis
Ethylene influence = – products get quick older
Ripenes: Lilium Transport to warm a box Ventilation is important to get cold air around flowers Heating flowers will result in waste Curved stems due to too warm transport Condensation in boxes gives Botrytis Conclusion: Cool chain very important A cool start most important
During flight
After arriving in Floward
– Directly in cold store after treatment
– Measure temperature en humidity
Advice: keep flowers cool and dry
Test Botrytis: measuring of spore pressure in air Step 1 / Day 1:
Write on the trays:
Location where these are placed, date and place
– Place the slides for 24-36 hours / open the dishes and put them down:
– Refrigerator
– Workshop, flower shop, barn
– Loudspeaker
– Sales space, presentation space / cash & carry
– Truck / truck / car
– Nursery or greenhouse etc
Step 2 / Day 2:
Close the bowls and write on them the date of closing
– Place the dishes at room temperature for 2-3 days
Stap 3 / Dag 4-6:
Read the results of the Botrytis spores pressure in the air:
– Compare the results with the reference photos
Botrytis test: 2 dagen open om sporen op te vangen uit de lucht
After 5-6 days closed the result is: how mores fungi how more bad is the situation with
Reference images of Botrytis spore pressure What to do after the products arrives at Floward? Controle boxes What to do when products arrives and checked ? 1. Threat the flowers
Cleaning and cutting 2. Directly on water
Flower food
3. Directly coldstore: – optimal temperatures
average 4-5 degrees if there is only 1 space Seperates spaces: one space 1-2 degrees and one space 4-6 degrees
between 70 – 80 %
Cold store temperatures + water level + vase live Exotic flowers in tropical cooler Anthurium Cymbidium Phalaenopsis + Vanda
Example workflow instruction Cambodia Storage of flowers Freshnesh of products in very important
FIFO = first in – first out
Reduce failure / waste
Old flowers / bad quality gives a negative name in the market of Floward
Quality Check after delivering Floward Sensitive flowers Flowers are packed in different sizes of boxes It depends in the type of product which box is used for which product.
Depends on: – Sensitivity – Heavy or light flowers – Fragile flowers
Cold sensitivity of flowers
Fixed amounts of flowers in a box is the best – By example: Astilbe always with 200 stems / box
Flowers are sometimes: light, heavy, fragile Heavy Light Fragile
Iris Eustoma = Lisianthus Helianthus
Hyacinthus Bouvardia Ornithogalum
Tulipa Astilbe Eremurus
Lilium Lathyrus
Lilium Longiflorum
Statice = Limonium Alstroemeria Allium
Solidago Delphinium Leucospermum
Groen Calla = Zantedeschia Celosia
Gladiolus Viburnum
Protea Hortensia = Hydrangea
Rosa
Transportschade Breakage sensitive products Following products are sensitive:
– Agapanthus
– Germini
– Zantedeschia / Calla
– Antirrhinum
– Hydrangea syn. Hortensia
– Dahlia
– Allium
– Leucospermum
– Celosia
– Ornithogalum (specially O. saundersiae and arabicum)
Cold sensitieve flowers Not in cold store! The following products are cold sensitive:
– Anthurium flowers + leafs
– Euphorbia
– Curcuma
– Heliconia
– Some leaf species:
Monstera
Philodendron
– Some Orchids a.o.
Vanda
Phalaenopsis
Paphiopedilum
They get extra attention during packaging with special aluminium bags
Cold damage Anthurium Chrysal flower food Cut flower food chain Pre-treatment Prof. T-Bags of Professional 2 +60% longer vase life Professional 2 Sachets / fluid
Grower Floward Transport Consumer Pre-treatment of cut flowers Influence on quality: After cut treatment Directly done after the crop of the flowers
Method it’s done on the nursery / farms
For some products it’s in the rules of the auctions
For some products it’s free to do it
Goal of after cut treatment:
Keep the best quality during the chain
The best result for consumers
Products are less sensitive for ………..
6 Different methods of after cut treatment 1. To reduce the sensitivity of ethylene
2. To give enough sugars / nutrients
3. Wilt after a dry period
4. Against yellow leaves
5. Against wound healing
6. Grown of bacteria in the water
Damage by Ethylene Dianthus Time laps video of pre-treated cut flowers Dianthus (= carnation) Delphinium Lilium LA Grp Lilium Oriental Grp You can watch this video in
Handling & treatment of cut flowers Handling flowers after arriving Take the products out of the box as soon as possible after delivery (because of Botrytis)
Prepare buckets with COLD water Use clean buckets with flower food
What’s in the buckets?:
• Clean water and flower food (Chrysal Prof 2)
Check:
• The water level in the buckets
• Some flowers drink a much water
Chrysal flower food Floward Use always the right concentration flowerfood • Overdosing can harm the flowers,
• While underdosing makes the products less effective.
For in Floward campanies: use a dosing unit The Chrysal Dosing Pump ensures proper dosing of flower care products.
Overdosing can harm flowers, while underdosing makes the products less effective.
Clean buckets Floward education plan
Why clean buckets? Flowers are sensitive for bacteria – Especially Gerbera, Rosa and “summer flowers”
The stem of flowers will be closed by the bacteria and water can’t go to the flower
The flowers starts to hang after several days
The vase live is dramatic decreased
Consumers are not satisfied with their flowers
Use clean tools To clean / disinfect regularly with Chrysal
Professional Cleaner: Knifes
Scissors
Tables
Clean machines
Use the right hardness of brooms
Stems of flowers Water direction in stem
Cutting edge
Bacteria in stem Bacteria The stems must be clean with the parts which is coming into the water. Otherwise:
bacteria Take away the thorns? It makes wounds on the stem.
Wounds give sugars out of the stem
Sugars coming into the water
Water with sugars lets grow bacteria explosive
Result: vase life of the roses is less
Effects bacteria on Rosa Allen water of water met chrysal
Effects bacteria on Eustoma Bouvardia after 8 days What helps against Bacteria? Use always:
– Clean vases, buckets or containers Desinfect with Chrysal Cleaner
– Clean & cold water
– Clean stems of the flowers Take away the leaves
Rosa: Take away thorns, only when this is necessary
Not damage the stems
Never use stripper, it damege the stems
What helps against Bacteria? Step by step: – Put into the water anti-bacterial:
Chrysal professional 2
Chlorine pill – Cut all the stems of flowers with a sharp and clean knife of scissor 3-5 cm – Put them directly into the water (not wait)
Consumers Always give flower food
Use the right concentration flowerfood
Always give advise how to use flowers at home of on locations
– Use Flower food
– Never in full Sun
– Never under airconditioner
Transport to consumers If possible organize:
– Cool transport: around 15 degrees is ok
– Use “Arrive alive” from Chrysal for transport
Some backgrounds: Botrytis Botrytis Botrytis grows specially when: Condensation in (unperforated)
cellophane
When temperature is higher is goes more quick
When product is spryed awith water
Warmth in packaging
When humidity is to high
When the product is moistly packaged
Temperature changes in the chain
When during handling products get wet / moisture:
• Wet / moisture tables etc
Before flowers go into a box Blow dry with an air pistol Sensitive flowers wrapped in paper
How to recognize Botrytis? Botrytis is a fungi:
– The spores are in the air,
specially in spaces which are not clean
– The spores start only to grow when there is an optimum in temperature and humidity
RV higher then 70 - 80 % is risky
– You can find it on:
flowers and plants and on each part of a product
– Flower, stems, leaves
– How more soft a product is how higher is the risk
Prevent Botrytis is important Give enough ventilation Give
Take flowers out of the boxes after they arrived Take
Prevent
Prevent changing of temperatures
• Condensation makes a high humidity in cellophanes
Never spray flowers with water Spray
Never give water over the head of the flowers Never
Perforated folie + sleeves Bigger holes are better Botrytis Rosa Botrytis in Rosa Botrytis after 5-7 days The grey mold is very infective Botrytis Gerbera Floward education plan
Botrytis video Grow spots or Botrytis? Such spots can be caused by a cold night during cultivation.
Such discussions are always difficult and it's hard to judge from a photo.
Botrytis has to be seen 'live' to be judged properly.
In such cases it is best to put the flowers in a vase with a plastic bag around the affected bud.
This will give an RV of 100% and if it is botrytis, the little dots will develop into real fungi.
Special explanation Rosa Chrysanthemum Gerbera Lilium Lisianthus Tulipa Narcissus Bouvardia Euphorbia Hippeastrum syn. Amaryllis Use determination tool Gebruik determinatietool Determination key Handy Excel sheet https://www.koppert.com/plant-pests
https://www.youtube.com/@Koppert_Global
6 most common animal infestations 6 most common animal infestations Aphid Whitefly
Mealybug + cap fluff
Caterpillar
Mobile Immobile
Recognize quality items Rosa Temperature and quality Botrytis Temperature and quality Ripeness Temperature and quality curved stems during warm transport Temperature and quality Grown flowers: high temp in box Thorn damaging Tip damaging Damaging by transport Residu Curved stems Not correct bunches Some examples of quality problems Assortment plants Availability plants Some basic care tips for plants Care: grow factors of plants Every plant needs te following:
Plants with succulent features = ability to survive dry periods. Features can be in: How much water or RV (%) does a plant need? By looking at a plant you already know a lot.
Looking at leaf thickness
• Soft leaf = lots of water + higher RH (more spraying)
• Thick / fat leaf = succulent properties in leaf
• little water, lower RH (less / no spraying)
Looking at stem / stem / root
• Succulent properties
• The more or the thicker the stem, the easier it is for the plant to grow.
• The thicker the root, the easier it is to care for / less water
• The finer the root, the more regular the water
RV te laag: bladpunten en randen When does a plant need water? Does soil on top of pot feel dry
Does pot feel heavy
Is the plant big or small
What is the leaf/stem ratio?
What time of year is it
Is it an herbaceous or woody
A fat or soft leafed species
Roots of plants tell something about….. Roots of plants tell something about….. Van regelmatig water en sproeien naar weinig water Temperature + fertilizers Temperature depends on:
– Area of origin: if you do not know search for it
– Often depends on which family the plant belongs
– Climate zone for the outdoor variety
Winter hardness
Frost sensitivity
Fertilizers:
– Depending on how much nutrition te grower give
– For the consumer:
Leaf plants in principle 1 x per month in the growing season
– In winter less, unless the plant remains in the living room
Flowering plants during flowering 1 x per 2 weeks
» After flowering please through away or give it rest for re-flowering ( no nutrition)
Cold sensitivity Lower temperature (around 5 degrees) How much light does a plant need? Which location By looking at a plant you already know a lot
You express the amount of in LUX
Look at the extend of green of the leaves
– The greener the leaves: the less light the plant need
– The more lack of green of the leaves= variegated: The more light the plant need No bright sun or direct sunlight
Light deficiency caused:: – Stretching of the plant
– Leaf or bud fall – Poor growth
Lichtbehoefte planten Hoe groener de plant des te minder licht hij kan staan (maar niet donker)
Minder bladgroen = meer licht. Bloeiende planten veel licht maar geen direct zonlicht
Groen Bont Bloeiend RV too low: leaf tips and edges Botrytis sensitivity (mould arising from spores and when plants become damp on leaves or flowers)
Cold damage / frost damage (garden) (depending on genus / cultivar) Cold damage / frost damage (garden) (depending on genus / cultivar) Follow up oktober: Questions and answers + Examn + Certificates Hope to see you in 2026 again. Or online or in real